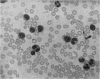

Full text
PDF







Images in this article
Selected References
These references are in PubMed. This may not be the complete list of references from this article.
- BAAR H. S. Interstitial plasmacellular pneumonia due to Pneumocystis carinii. J Clin Pathol. 1955 Feb;8(1):19–24. doi: 10.1136/jcp.8.1.19. [DOI] [PMC free article] [PubMed] [Google Scholar]
- BIRD T., THOMSON J. Pneumocystis carinii pneumonia. Lancet. 1957 Jan 12;272(6959):59–64. doi: 10.1016/s0140-6736(57)90251-9. [DOI] [PubMed] [Google Scholar]
- DEAMER W. C., ZOLLINGER H. U. Interstitial plasma cell pneumonia of premature and young infants. Pediatrics. 1953 Jul;12(1):11–22. [PubMed] [Google Scholar]
- GAJDUSEK D. C. Pneumocystis carinii; etiologic agent of interstitial plasma cell pneumonia of premature and young infants. Pediatrics. 1957 Apr;19(4 Pt 1):543–565. [PubMed] [Google Scholar]
- JIROVEC O., VANEK J. Zur Morphologie der Pneumocystis carinii und zur Pathogenese der Pneumocystis-Pneumonie. Zentralbl Allg Pathol. 1954 Nov 20;92(10-11):424–437. [PubMed] [Google Scholar]
- LE TAN VINH La pneumonie à pneumocystis; ses rapports avec la pneumonie interstitielle à plasmocytes. Arch Fr Pediatr. 1954;11(10):1035–1054. [PubMed] [Google Scholar]
- LOEB V., Jr, MOORE C. V., DUBACH R. The physiologic evaluation and management of chronic bone marrow failure. Am J Med. 1953 Oct;15(4):499–517. doi: 10.1016/0002-9343(53)90140-5. [DOI] [PubMed] [Google Scholar]
- Pines B., Lederer M. Osteopetrosis: Albers-Schönberg Disease (Marble Bones): Report of a Case and Morphologic Study. Am J Pathol. 1947 Sep;23(5):755–781. [PMC free article] [PubMed] [Google Scholar]
- RUSSELL J. G. Pneumocystis pneumonia associated with agammaglobulinaemia. Arch Dis Child. 1959 Aug;34:338–341. doi: 10.1136/adc.34.176.338. [DOI] [PMC free article] [PubMed] [Google Scholar]
- SIEGEL B. M., FRIEDMAN I. A., SCHWARTZ S. O. Hemorrhagic disease in osteogenesis imperfecta; study of platelet functional defect. Am J Med. 1957 Feb;22(2):315–321. doi: 10.1016/0002-9343(57)90016-5. [DOI] [PubMed] [Google Scholar]
- SJOLIN S. Studies on osteopetrosis. II. Investigations concerning the nature of the anaemia. Acta Paediatr. 1959 Nov;48:529–544. doi: 10.1111/j.1651-2227.1959.tb16419.x. [DOI] [PubMed] [Google Scholar]
- TURANO A. F., FAGAN K. A., CORBO P. A. Variations in clinical manifestations of osteopetrosis: report of two cases. J Pediatr. 1954 Jun;44(6):688–694. doi: 10.1016/s0022-3476(54)80012-6. [DOI] [PubMed] [Google Scholar]
- VANEK J., JIROVEC O. Parasitäre Pneumonie. Interstitielle Plasmazellenpneumonie der Frühgeborenen, verursacht durch Pneumodystis Carinii. Zentralbl Bakteriol Parasitenkd Infektionskr Hyg. 1952 May 12;158(1-2):120–127. [PubMed] [Google Scholar]